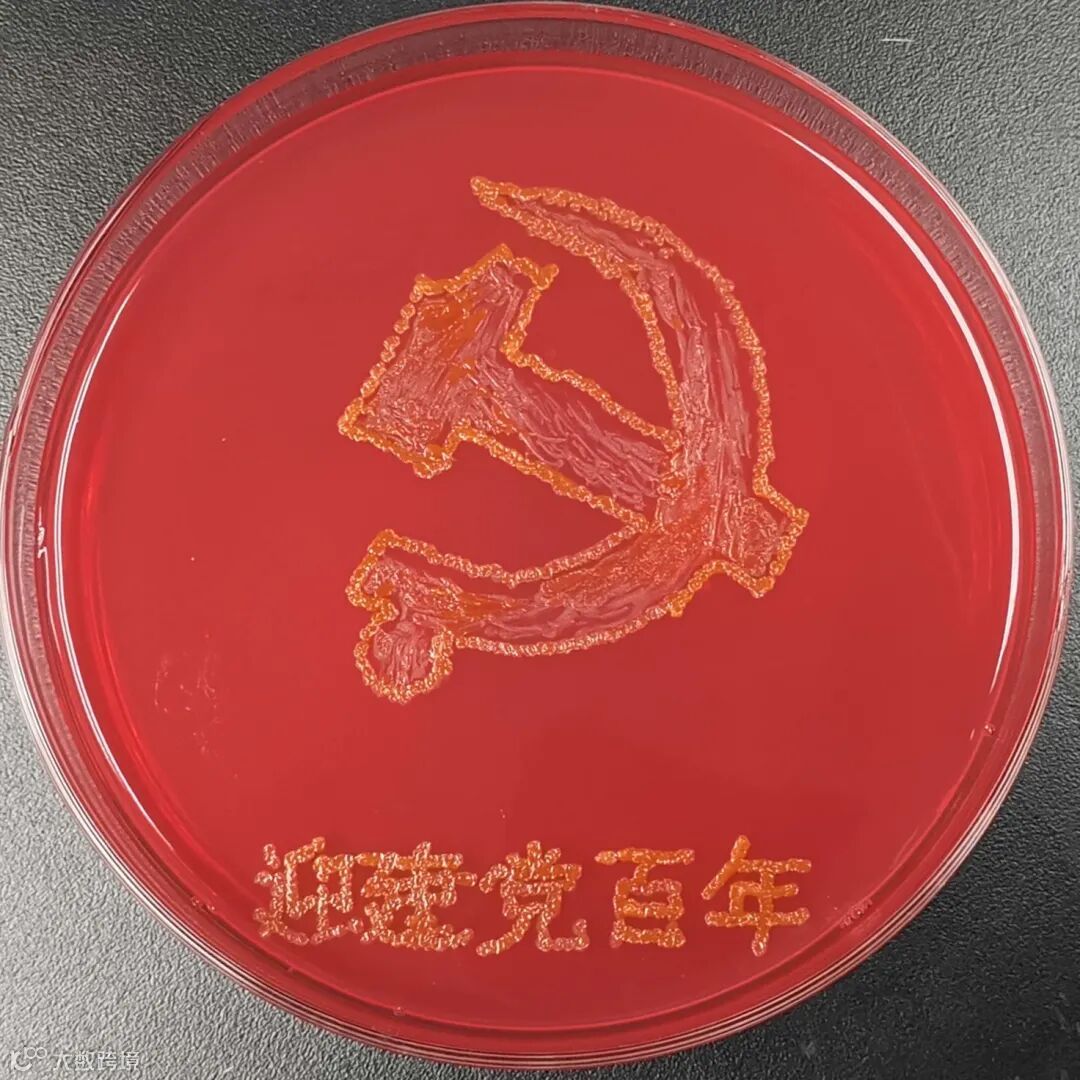
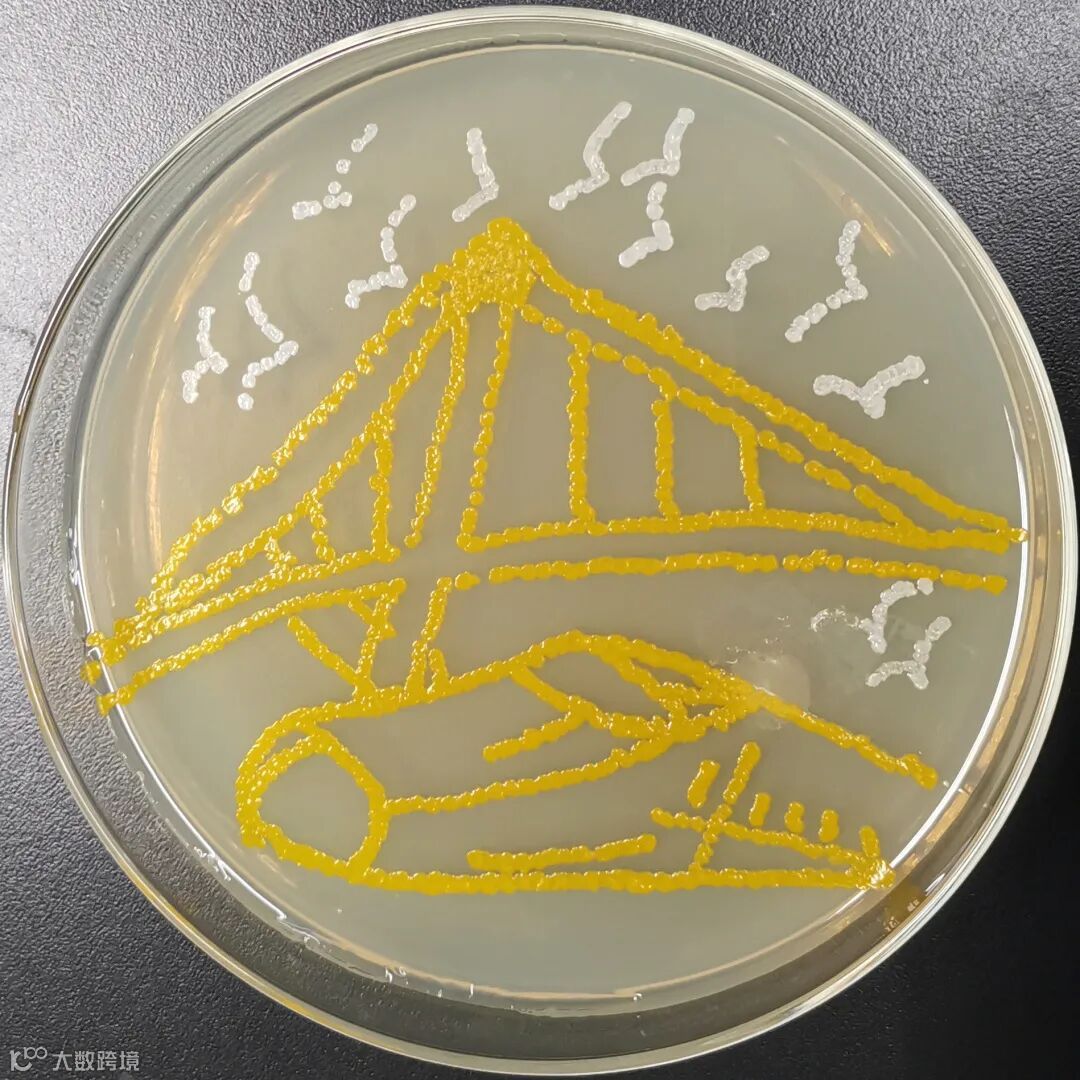

师生自制疫情防控
日常行为微视频
近日,为帮助师生做好日常防护,江苏大学拍摄制作了疫情防控日常行为微视频,对师生工作生活中如社交距离、手部清洁、推门、按电梯等常见行为进行规范指导,让师生养成正确的卫生行为习惯,齐心协力做好防疫。
别出心裁的
“微生物画”
为庆祝建党100周年,近日,南通大学生命科学学院师生发挥专业特色,精心选取了建党、抗战胜利、建国、改革开放、神舟载人飞船升空等大事件时间节点制作成微生物画,歌颂党的丰功伟绩,祝愿我们的祖国更加欣欣向荣、繁荣昌盛。

寒假“大礼包”
惊喜登场
近日,高邮市汪曾祺学校小学部精心为孩子们准备了一份寒假“大礼包”。看,有文具用品、表扬信、免写券、小零食、手绘漫画卡片等,温情满满又科学实用。孩子们拿到奖励,小脸上露出了惊喜。



留校过寒假
安心又舒心
因疫情影响,今年寒假,江苏海洋大学共有22名学生留校。为此,学校多部门密切配合,周密安排,确保同学们度过一个安全舒适充实的假期。学校不仅为留校的困难学生发放500-800不等的临时困难补助,还送上防“疫”礼包,内有30只口罩、体温计、84消毒液、酒精洗手液。留校的同学被集中安排住宿,基本都是单人间或双人间,全部配有空调、电热水器,确保大家住的安全舒心。



近日,常州大学举行寒假留校中外学生慰问会。学院领导给学生发放春节礼包、牛奶和防疫用品,并与中外学生一起写福字、写对联。寒假期间,各学院也将积极举办系列活动来丰富学生寒假生活,如每周安排两次集体活动,有运动类的羽毛球、乒乓球、跳绳比赛;也有看春晚、猜灯谜、包汤圆活动,希望中外学生一起过中国年,感受到“常大”家一般的温暖。



来源:学校投稿
编辑:王筱
审核:管钰






